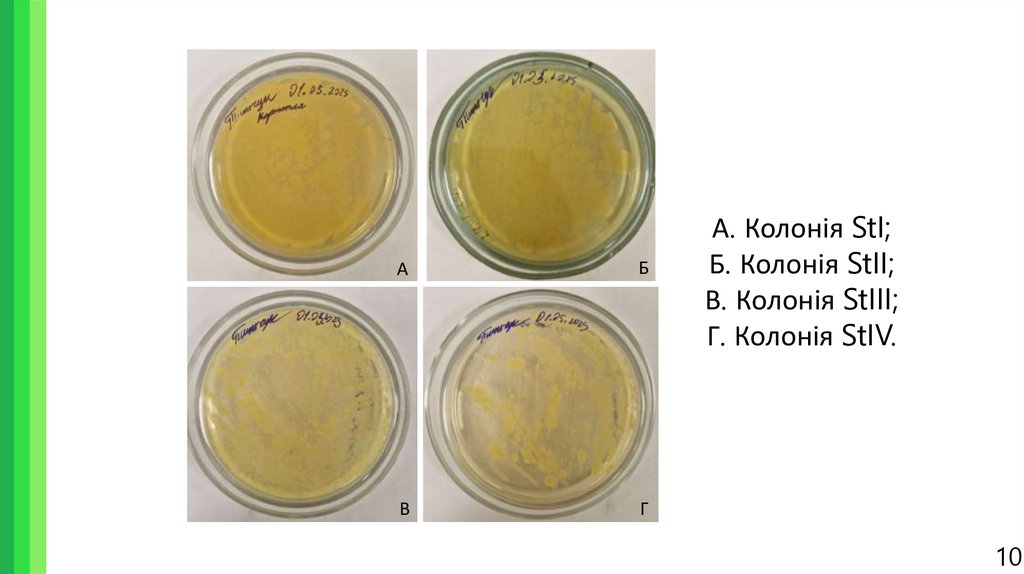

Similar presentations:
Виділення фітопатогенних бактерій Solanum tuberosum L
1. Виділення фітопатогенних бактерій Solanum tuberosum L.
Національний університет біоресурсів та природокористування УкраїниФакультет захисту рослин, біотехнологій та екології
Кафедра екобіотехнології та біорізноманіття
Виділення фітопатогенних
бактерій Solanum tuberosum L.
Доповідач: Тиньчук Антон Олександрович
Науковий керівник: к. б. н., доцент, завідувач кафедри
екобіотехнології та біорізноманіття
Кваско Олена Юріївна
Київ - 2025
2. Актуальність теми
Картопля (Solanum tuberosum) – рослина роду пасльонових, яка є однією зосновних харчових культур в Україні, з третім у світі показником врожаю в 21,36
млн. т. у 2023 році згідно FAO. Відповідно, дослідження та подальший контроль
патогенів картоплі є критичним для продовольчої безпеки України.
• Закон про карантин рослин визначає перелік шкідливих організмів, поширенню яких потрібно
запобігати, серед них і бактеріальні фітопатогени.
• Бактеріальні фітопатогени поширені в Україні, та вражають бульби як в полях, так і в місцях
тривалого зберігання.
• Зміни клімату створюють загрозу поширення раніше рідкісних в Україні патогенів, таких як
Ralstonia solanacearum.
2
3.
Об’єктом досліджень є ідентифікація бактеріальниих фітопатогенівSolanum tuberosum та її методи.
Предметами досліджень є бактеріальні фітопатогени Solanum
tuberosum.
Дослідження були проведені на базі лабораторій кафедри
екобіотехнології та біорізноманіття факультету захисту рослин,
біотехнологій та екології Національного університету біоресурсів і
природокористування України.
3
4. Мета та задачі
Метою наукової роботи було виділити та ідентифікувати фітопатогени Solanumtuberosum.
Було визначено наступні задачі:
1. Відібрати бактеріальні культури з рослин Solanum tuberosum, виділити чисті
культури фітопатогенів та визначити патогенність виділених фітопатогенних
бактерій.
2. Дослідити морфо-фізіологічні та біохімічні властивості виділених
фітопатогенних бактерій.
3. Провести молекулярно-генетичний аналіз отриманих фітопатогенних бактерій.
4
5. Clavibacter michiganensis
БА
В
А. Ураження бульб кільцевою гниллю картоплі; Б. Ураження куща
картоплі при кільцевій гнилі картоплі; В. Колонії Clavibacter
michiganensis.
5
6. Pectobacterium atrosepticum та Dickeya sp.
АБ
В
Г
А. Ураження приґрунтового стебла чорною ніжкою картоплі; Б. Ураження бульби картоплі
м’якою гниллю картоплі; В. Колонії Pectobacterium atrosepticum; Г. Колонії Dickeya solani.
6
7. Ralstonia solanacearum
АБ
В
А, Б. Ураження бульб картоплі бурою гниллю картоплі; В. Колонії Ralstonia solanacearum
7
8. Використані методи
Для ідентифікації фітопатогенів було використано такі методи:• Морфо-фізіологічні – візуальний огляд за допомогою фарбування за Грамом,
дослідження культуральних властивостей та дослідження патогенності та
гіперчутливості.
• Біохімічні – тести на пектолітичну активність, утворення сірководню, на
каталазу та оксидазу, тест гідроксидом калію, тест на виділення кислот та на
антибіотикорезистентність.
• Молекулярно-генетичні – полімеразно-ланцюгова реакція з використанням
специфічних праймерів.
8
9. Виділення ізолятів
Було відібрано бульби картоплі, потенційнозаражені фітопатогенами, з господарчих ділянок у
Рівненській, Хмельницькій та Київській областях.
З уражених ділянок було зроблено гомогенізат,
який потім було внесено до картопляного агару.
Було отримано чотири життєздатні посіви, які
містили в собі різні види бактерій.
В подальшому, з отриманих консорціумів було
виділено чисті бактеріальні ізоляти, які могли бути
фітопатогенами.
А
А. Відібрані колонії фітопатогенів; Б. Зразок з
ураженої ділянки бульби.
Б
9
10.
АБ
В
Г
А. Колонія StI;
Б. Колонія StII;
В. Колонія StIII;
Г. Колонія StIV.
10
11. Тест на патогенність
Було проведено тест на патогенність шляхом введення рідких бактеріальнихсуспензій досліджуваних ізолятів через поверхню стерильними голками, або через
поранення. В результаті, патогенні властивості проявили ізоляти StI, StII та StIII
А. Бульба, інокульована внесенням ізоляту StI через голку;
Б. Бульба, інокульована ізолятом StIII через поранення.
1
12. Тест на гіперчутливість
Тест на гіперчутливість проводився шляхом інокуляції листя здорових кущів тютюну сорту Самсун,вирощених на стерильному ґрунті в спеціально відведених ділянках теплиці. Інокуляцію
проводили бактеріальною рідиною на основі виділених ізолятів. В результаті гіперчутливість
викликали ізоляти StI, StII та StIII.
А
Б
В
Г
Д
Прояви реакції надчутливості:
А. Неінфіковане листя; Б. Негативний контроль, інокульований стерильною
водою; В, Г, Д. Листя, інокульовані ізолятами StI, StII та StIII, відповідно.
12
13. Огляд морфології
А№ штаму
Колір колоній
Текстура колоній
Фарбування за
Грамом
StI
Жовто-білий
Глянцеві, випуклі
Грамнегативні
StII
Жовто-білий
Глянцеві, випуклі
Грамнегативні
StIII
Жовто-білий
Глянцеві, випуклі
Грамнегативні
StIV
Кремово-білий
Глянцеві, випуклі
Грамнегативні
Б
В
А. Вигляд колоній під мікроскопом; Б. Культура ізоляту StII; В. Культура ізоляту StIII
13
14. Біохімічні тести
Було проведено наступні біохімічні тести:1. Тест на пектолітичну активність;
2. Тест на утворення сірководню;
3. Тест на каталазу;
4. Тест на оксидазу;
5. Тест на гідроксид калію;
6. Тест на гідроліз желатину;
7. Тест на ріст при 36-37°С;
8. Тест на виділення кислот;
9. Тест на чутливість до еритроміцину та стрептоміцину.
14
15. Тест на пектолітичну активність
Пектолітичну активність визначали шляхом розміщення на тонких скибках здорової картопліпаперових дисків, просякнутих бактеріальною рідиною отриманих ізолятів, з подальшою
інкубацією впродовж 2-3 днів за температур в 20, 25 і 30°C. В ході тесту було виявлено, що StI,
StII та StIII проявляли однакову активність за однакових умов.
Прояви мацерації на прикладі ізоляту StII:
А. Мацерація за 20°C; Б. Мацерація за 25°C; В. Мацерація за 30°C.
15
16.
Біохімічний тестStI
StII
StIII
StIV
Утворення
сірководню
+
+
+
+
Каталазний тест
+
+
+
-
Оксидазний тест
-
-
-
-
Тест гідроксидом
калію
+
+
+
-
Гідроліз желатину
+
+
+
-
Ріст при 36-37°С
+
+
+
+
Пектолітична
активність
+
+
+
+
Виділення кислот
+
+
+
-
Чутливість до
еритроміцину
-
-
-
+
Чутливість до
стрептоміцину
+
+
+
-
16
17. Молекулярно-генетичний аналіз
ПЛР-тестування проводилось на основі гену пектатліази pelY, було використано таку парупраймерів:
5’ TАACCGGACGCCGAGCTGTGGCGT 3’
5’ CAGGAAGATGTCGTTATCGCGAGT 3’
За параметрів:
Етап ампліфікації
Температура, °С
Час, с
Кількість циклів
Початкова денатурація
94
180
1
Денатурація
94
30
35
Відпал праймерів
94
30
35
Елонгація
72
30
35
Кінцева елонгація
72
М
1
300
2
3
П
1
Н
17
18. Результати ПЛР-тестування
2000 пн1500 пн
1000 пн
500 пн
434 пн
М
1
2
3
П
Н
М – ДНК-маркери;
1 - ДНК StI;
2 – ДНК StII;
3 – ДНК StIII;
П – Позитивний контроль
(стандартний штам P.
carotovorum);
Н – Негативний контроль
(стандартний штам E.
chrysanthemi);
Стрілкою вказано сегмент ДНК
в 434 пн.
18
19. Апробація
2000 пн1500 пн
1000 пн
500 пн
М
1
2
3
П
Н
19
20. Висновки
1.Доведено, що ізоляти бактерій StI, StII та StIII, що були виділені із заражених зразків
картоплі, проявляють патогенність та, зокрема, спричиняють розвиток бактеріального
захворювання на інокульованих бульбах картоплі, проявляють пектолітичну активність на скибках
картоплі, з найвищою активністю при інкубуванні за температури в 25 та 30°C, а також
викликають реакцію надчутливості у кущів тютюну після їх інокуляції суспензіями досліджуваних
бактеріальних ізолятів. Ізолят StIV не проявляє ознак патогенності, отже не належить до збудників
бактеріозів
Solanum
tuberosum.
2.
Визначено, що ізоляти StI, StII та StIII формували жовто-білі випуклі колонії, є
грамнегативними та проявили позитивні реакції на метиловий червоний, тест на каталазу, тест на
КОН і тест на пектолітичну активність, росли при 36-37°C, виділяли сірководень, гідролізували
желатин, та негативно реагували за Грамом, проявили стійкість до еритроміцину та чутливість до
стрептоміцину. Такі результати дали можливість припустити, що дані ізоляти належать до
фітопатогенів
роду
Pectobacterium.
3.
В результаті ампліфікації ДНК зі специфічними праймерами для послідовності гена pelY
виявили, що отримані ізоляти бактерій (StI, StII та StIII) належать до роду Pectobacterium.
20

biology
biology








